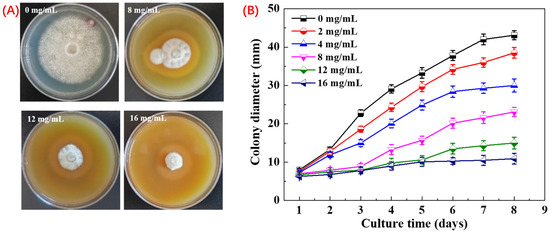
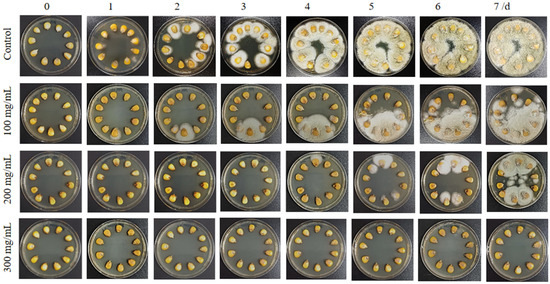

Abstract
Maize, one of the most widely cultivated crops globally, is highly susceptible to mycotoxin contamination. In this study, an endophytic strain Pseudomonas sp. HP-1, isolated from Peganum harmala L., demonstrated significant biocontrol potential. The culture extract of Pseudomonas sp. HP-1 (PHE) exhibited strong antifungal activity, with inhibition zones of 40.07 ± 0.21 mm against Penicillium italicum, 29.71 ± 0.25 mm against Aspergillus niger, and 23.10 ± 0.44 mm against A. flavus, along with notable antibacterial activity against Staphylococcus aureus (22.43 ± 0.55 mm). At a concentration of 16 mg/mL, PHE almost completely inhibited the mycelial growth of A. flavus. The antifungal mechanism of PHE was investigated through scanning electron microscopy (SEM) and propidium iodide (PI) staining analysis, which demonstrated that antifungal activity is primarily through the disruption of cellular membrane integrity. Furthermore, PHE significantly reduced the incidence of A. flavus contamination in agroecological maize seeds during storage, and treated PHE showed superior antifungal efficacy compared to non-treated PHE, highlighting its potential as an effective antifungal agent for seed protection. Through one- and two-dimensional NMR and MS analyses, the primary active compound of PHE was identified as 1-phenazinecarboxylic acid. These findings indicate that PHE can be utilized as a sustainable antifungal agent for protecting maize seeds against mycotoxin-producing fungi.
1. Introduction
Maize (Zea mays L.), a globally vital food and feed crop, is a key source of dietary protein and calories [1]. In China, maize is the second largest grain crop, with an annual production of 260 million tons (2016–2020) and an area under cultivation of more than 40 million hectares [2]. However, post-harvest losses pose a significant challenge, with an estimated 2.4% annual loss attributed partly to fungal contamination during storage [3]. Fungal spoilage and mycotoxin contamination are pervasive issues in cereals and cereal-based products, with risks escalating throughout the supply chain, from cultivation to processing [4].
Fungal contamination of maize is caused by a diverse range of species, with over 20 reported, including Aspergillus, Fusarium, Alternaria, Penicillium, and Stenocarpella being the most prevalent [5]. These fungi not only deplete maize nutrients but also produce mycotoxins, posing serious health risks to humans and animals [6]. Among them, A. flavus is a major threat during maize storage, causing significant economic losses through aflatoxin production, which affects seed germination, metabolic processes, and nutritional value [7]. The infection rate of A. flavus can reach 10–20% during initial storage and escalate to 54–79% after six months [8]. Furthermore, fungal infection often initiates in the seed and root system, subsequently spreading to internodes, stems, and ears, leading to severe crop damage [9].
Traditional control methods rely heavily on chemical seed treatments, which raise concerns regarding environmental toxicity and human health risks [10]. Although new antifungal agents and synthetic preservatives have been introduced, their overuse has led to increased fungal resistance and environmental harm [11]. For instance, chemical fungicides like phytoconazole and phenyl ether metronidazole have been linked to adverse effects on ecosystems and non-target organisms [12]. The development of resistant fungal strains, ecological damage, and residual toxicity has further highlighted the limitations of synthetic chemicals [13]. In response to these challenges, there is growing interest in biological control methods as sustainable alternatives to synthetic fungicides [14]. Microbial biocontrol agents, particularly those producing antimicrobial metabolites, have gained attention for their potential in managing fungal infections [15]. For example, bacillomycin D from Bacillus sp. has demonstrated strong antifungal activity, reducing deoxynivalenol levels in stored maize [16]. Similarly, antifungal metabolites from Streptomyces sp. RL-1-178 have shown efficacy in inhibiting mycotoxin production during maize storage [17].
Peganum harmala is a perennial herbaceous plant native to Central Asia, North Africa, and the Middle East. Its primary bioactive compounds, β-carboline alkaloids, exhibit potent broad-spectrum antimicrobial activity against diverse bacterial and fungal pathogens [18]. Notably, Pseudomonas species dominate the symbiotic microbiome of P. harmala, many of which display antagonistic effects against pathogenic bacteria [19]. This antimicrobial activity may be attributed to secondary metabolites produced by Pseudomonas, such as pseudotrienic acids A and B (isolated from Pseudomonas sp. MF381-IODS), which inhibit S. aureus and P. syringae (MIC = 70 µg/mL for both) [20]. Furthermore, Pseudomonas sp., known for their role in plant disease control, produce a wide array of bioactive secondary metabolites, including phenazines, phloroglucinols, pyoluteorins, pyrrolnitrins, cyclic lipopeptides, hydrogen cyanide, lytic enzymes, and volatile organic compounds [21,22]. Despite their potential, limited research has explored the application of Pseudomonas sp. metabolites in maize grain storage. This study aims to (1) investigate the antimicrobial activity of metabolites from Pseudomonas sp. HP-1; (2) evaluate the efficacy of Pseudomonas sp. HP-1 extracts in preserving maize grain infected with A. flavus; and (3) identify the major antifungal compounds produced by Pseudomonas sp. HP-1.
2. Materials and Methods
2.1. Chemicals and Instrument
All chemicals and reagents used in this study were of analytical grade. Methanol, ethanol, dichloromethane, acetonitrile, Dimethyl sulfoxide (DMSO), and 1-butanol were obtained from Shanghai Titan Scientific Co., Ltd. (Shanghai, China). Culture media, including Luria-Bertani medium (LB), Potato Dextrose Agar medium (PDA), Mueller-Hinton Agar medium (MHA), and Mueller-Hinton Broth medium (MHB) were obtained from Qingdao Rishui Biotechnology Co., Ltd. (Qingdao, China). The following instruments were utilized in this study: a Nuclear Magnetic Resonance spectrometer (NMR, AVANCE NEO 600, Bruker, Germany), a High-Performance Liquid Chromatography system (HPLC, Agilent 1260, Agilent Technologies, Waldbronn, Germany), and a High-Resolution Mass Spectrometer (HR-MS, Ultimate 3000/Q-Exactive, Thermo Fisher Scientific, Waltham, MA, USA).
2.2. Isolation of the Strain HP-1
The strain HP-1 was isolated from the rhizosphere soil of Peganum harmala L. collected from Shirengou Village, Shuimogou District, Urumqi, Xinjiang, China (latitude 43°49′9″ N, longitude 87°46′27″ E). Soil samples were serially diluted under aseptic conditions, and the resulting suspension was spread onto Luria–Bertani (LB) agar plates. The plates were incubated at 25 °C for 14 days, after which a single colony was isolated and cultured on fresh LB agar medium to obtain a pure culture of strain HP-1. The strain HP-1 was identified through 16S rRNA gene sequencing. Universal primers 27F (5′-AGAGTTTGATCMTGGCTCAG-3′) and 1492R (5′-TACGGYTACCTTGTTACGACTT-3′). PCR products were sequenced by General Biosystems (Anhui), and the resulting sequences were analyzed using the NCBI BLAST algorithm (BLAST+, v2.16.0+) for similarity assessment. The 16S rRNA gene sequences have been deposited in the NCBI database with corresponding accession numbers.
2.3. Preparation of Culture Extract (PHE)
The strain HP-1 was cultured on LB agar medium at 30 °C for 4 days to ensure active growth. Subsequently, the strain was inoculated into a 500 mL conical flask containing 100 mL of SM seed medium (composed of soluble starch 1.0%, glucose 0.5%, tryptone 0.5%, yeast extract 0.2%, CaCO3 0.3%, MgSO4·7H2O 0.05%, and K2HPO4 0.1% in distilled water). The flask was incubated in a thermostatic shaker at 30 °C and 180 rpm for 4 days. Following seed culture preparation, 5 mL of the seed culture was transferred into fifteen 1000 mL conical flasks, each containing 200 mL of XM-3 production medium (composed of soluble starch 2.0%, glucose 0.5%, glycerol 2.0%, yeast extract 0.3%, polypeptone 1.5%, and HP20 1.0% in distilled water). The inoculated flasks were incubated on a shaker at 30 °C and 180 rpm for 7 days. After the fermentation period, 200 mL of 1-butanol was added to each flask, and the mixture was stirred for 1 h. The resulting mixture was centrifuged at 6000 rpm for 10 min to separate the organic layer from the aqueous layer containing mycelium. The organic solvent was evaporated under reduced pressure, yielding 4.2 g of crude extract from 3 L of culture broth.
2.4. HPLC-DAD Analysis of Culture Extracts
Analysis of the main chemical constituents of PHE by HPLC-DAD with minor modification according to the method of Yasmo Perez et al. [23]. The HPLC analysis was performed using a ZORBAX EC-C18 column (Agilent, Santa Clara, CA, USA, 4.6 × 150 mm, 4 μm) maintained at 32 °C. Detection was carried out using a diode array detector (DAD, Agilent, Waldbronn, Germany). The mobile phase consisted of 0.1% (v/v) formic acid in distilled water (solvent A) and acetonitrile (solvent B). The flow rate was set at 1 mL/min, and the injection volume was 100 μL. The total run time was 32 min, with gradient elution programmed as follows: 0–3 min, 5% B; 3–24 min, 5–85% B; 24–29 min, 85% B; and 29–32 min, 85–5% B.
2.5. Antimicrobial Effect of PHE
2.5.1. Antibacterial Activity
The antibacterial activity against bacteria was determined using the Kirby–Bauer method [24] against two model strains, E. coli and S. aureus. Further, the stock cultures of bacteria were grown in the MHB medium at 37 °C for 24 h. The turbidity of the grown culture was adjusted with sterile water to 0.5 McFarland standard and diluted to 1 × 106 CFU/mL of equivalent bacterial cells with sterile water. An aliquot (100 μL) of microbial suspension was spread on the surface of MHA media. The PHE was dissolved in DMSO to achieve a concentration of 2 mg/mL, and filter paper discs of 6 mm diameter were loaded with the PHE extracts and kept on MHA media plates. To evaluate the antibacterial potential of the PHE, kanamycin and dimethyl sulfoxide (1 mg/mL) were used as positive and negative controls, respectively. Finally, the media plates were placed in an incubator at 30 °C for 24 h, and the zones of inhibition were recorded in millimeters.
2.5.2. Antifungal Activity
To evaluate the antifungal activity of PHE against yeasts, C. albicans and three predominant fungal cultures, A. flavus, A. niger, and P. italicum were used, wherein C. albicans used the Kirby–Bauer method, as described above. The agar well diffusion method was used to detect antifungal activity [25]. Spore counts of 1 × 106 spores/m were obtained according to standard procedures for hemocytometer calculation. Fungal suspensions were placed in flasks containing 30 mL of sterile PDA at 50 °C with a spore count of 1 × 106 spore/mL, and 6 mm diameter wells were punched out from the agar plate. The 100 μL of diluted PHE (10 mg/mL, dissolved in DMSO) was dispensed into each agar well in an MHA plate. The 100 μL of DMSO and Ampicillin B (1 mg/mL) served as negative and positive controls. The antibacterial activity was evaluated according to the inhibitory zone diameter after 24 h at 30 °C incubation (DMSO inhibitory effect subtracted).
2.5.3. Inhibition of the Mycelial Growth Rate of A. flavus
The method proposed by Bluma and Etcheverry, with slight modification, was used to assess the effect of crude extracts on the growth rate of A. flavus filaments [26]. Briefly, PHE (dissolved in DMSO) was added to PDA (50 °C) to obtain solid culture medium containing 2 mg/mL, 4 mg/mL, 8 mg/mL, 12 mg/mL, and 16 mg/mL of PHE, respectively. After solidification, the agar block of A. flavus (6 mm) was placed in the center of the PDA plate containing the PHE. Control plates were PDA mixed with DMSO (1 mL) and the center was similarly inoculated with an agar block of A. flavus. Three groups each of treatment and control were incubated at 30 °C for 7 days and the whole experiment was repeated three times. The inhibitory rate was calculated according to the following formula:
Rc is the average diameter of the control and the Rt is the average diameter of the treatment colony, respectively.
2.5.4. Observation of Mycelium Morphology
Morphological changes in mycelium in the treatment groups were observed by scanning electron microscopy (SEM). A. flavus mycelia were obtained by culturing A. flavus spores (106/mL) in 10 mL ×3 of SM medium (soluble starch 1.0%, glucose 0.5%, tryptone 0.5%, yeast extract 0.2%, CaCO3 0.3%, MgSO4·7H2O 0.05%, K2HPO4 0.1% added to distilled water) at 30 °C for 48 h. Fungal suspensions were treated with PHE (0, 8, 12, and 16 mg/mL) at 37 °C for 48 h. Briefly, mycelia were fixed with glutaraldehyde in phosphate-buffered saline (PBS) at 4 °C for 24 h, and dehydrated in ethanol for 15 min at each different concentration. Finally, the samples were freeze-dried, sprayed with gold, and observed through SEM.
2.5.5. Determination of Cell Membrane Damage
The effect of PHE on cell wall integrity was measured using the method of propidium iodide (PI) staining [27]. In brief, A. flavus was incubated for seven days prior to treatment as outlined in Section 2.5.3. The untreated mycelia were used as a control group. The untreated mycelia were used as a control group. Mycelia were dyed with 25 μg/mL propidium iodide (PI) in the dark for 30 min at 37 °C and then washed three times and resuspended in PBS. Subsequently, fluorescence was detected by fluorescence microscopy (Leica DM3000-LED, Wetzlar, Germany).
2.6. Biocontrol Potential of PHE Against A. flavus on Maize Seeds
The maize samples were obtained from a local supermarket and sieved to remove impurities and randomly divided into four portions, each of 10 capsules. Before testing, the maize seeds were surface-sterilized by immersing them in a 0.05% sodium hypochlorite solution for 1 min, followed by several rinses with sterile distilled water. After drying the maize seeds in a sterile environment, each maize seed was infiltrated in the A. flavus solution of A. flavus (1 × 106 spore/mL) for 10 min to ensure that each seed was completely contaminated. Each group of maize seeds was then treated with the solutions of PHE (100, 200, 300 mg/mL) and mixed for 5 min. Each set of maize seeds was laid flat in Petri dishes with PDA medium and incubated at 30 °C for 7 days for observation. DMSO was used as control and each treatment consisted of three replicates.
2.7. Isolation and Purification of Antibacterial Compounds
The crude extract PHE (3.0 g) was subjected to silica gel column chromatography with a step gradient of CH2Cl2/MeOH (1:0, 20:1, 10:1, 4:1, 2:1, 1:1, and 0:1 v/v). Fraction 2 (20:1) was concentrated to provide 85.5 mg of dried material containing the target compounds. The final purification was achieved by preparative HPLC (Agilent, Santa Clara, CA, USA, ZORBAX SB-C18, 9.4 × 250 mm, 5 μm), 4 mL/min, UV detection at 254 nm, eluted with a mixture of MeCN and 0.1% HCO2H solution (55:45) to yield HP-1 A (27 mg, tR 8.0 min).
2.8. Statistical Analysis
Each test was conducted three times, and the mean ± standard deviation (X ± SD) was used to calculate the results. All data were analyzed by one-way analysis of variance (ANOVA) to determine the significance by IBM SPSS (Version 26.00) and plotted by Origin 2022.
3. Results and Discussion
3.1. Screening and Identification of Strain Pseudomonas sp. HP-1
Six soil samples were gathered from the rhizosphere soil of Peganum harmala L. All strains were isolated from soil samples by dilution spread plates on LB agar. These strains were cultured and fermented to obtain butanol extracts of the culture broths, which were analyzed by HPLC-DAD. It is noteworthy that the HPLC data for strain HP-1 had a high absorption peak at retention time 13.6 min, which showed characteristic absorbance at 200, 250, and 372 nm (Figure S1). Preliminary screening was conducted for the antimicrobial activity of PHE, which revealed significant antimicrobial activity. Consequently, strain HP-1 was selected as the target of this study. Moreover, the isolated strain HP-1 was identified as a member of the genus Pseudomonas on the basis of 98.4% similarity in the 16S rDNA gene sequence (873 nucleotides; DDBJ accession number PQ803664) to Pseudomonas fluorescens Dk3 (accession number KT377434). Plant symbiotic bacteria play a crucial role in protecting host plants from pathogenic microorganisms [28]. Some symbiotic bacteria are capable of producing antimicrobial metabolites, such as antibiotics, enzymes, or volatile organic compounds, which directly inhibit or kill pathogenic bacteria [29].
3.2. Antimicrobial Evaluation of PHE Against Microorganisms
The antimicrobial activity of the extracts was evaluated against six model strains using the agar well diffusion assay, including three fungi (A. flavus, A. niger, and P. italicum), two bacteria (E. coli and S. aureus), and one yeast (C. albicans). As illustrated in Figure 1, the PHE exhibited strong antifungal activity, with inhibition zones of 23.1 ± 0.44 mm, 29.71 ± 0.25 mm, and 40.07 ± 0.21 mm against A. flavus, A. niger, and P. italicum, respectively. Additionally, PHE showed notable antibacterial activity against S. aureus (22.43 ± 0.55 mm) but showed minimal activity against E. coli. The strong antifungal activity of PHE, particularly against P. italicum and A. flavus, highlights its potential as a sustainable biocontrol agent for protecting crops like maize from mycotoxin-producing fungi. Microorganisms synthesize antimicrobial compounds as secondary metabolites, such as PHE, which confer competitive advantages by inhibiting or eliminating competing microbial species. These bioactive substances exert their effects through multiple mechanisms, including inhibition of cell wall biosynthesis and disruption of cell membrane integrity. Pseudomonas sp. has been widely used as a model organism for biocontrol of plant diseases [30]. Such as Pseudomonas syringae strains ESC-10 and ESC-11 were successfully used to prevent post-harvest fungal diseases of citrus, pears, drupes, and potatoes during storage [31]. The ability of Pseudomonas to produce a range of antimicrobial agents (e.g., phenazines, phloroglucinols, pyrrolnitrins, and cyclic lipopeptides) that can antagonize fungal plant pathogens may be one of the main reasons [32].

Figure 1.
Inhibitory zone formed around the PHE against the six model strains. (A) PHE against E. coli. (B) PHE against S. aureus. (C) PHE against C. albicans. (D) PHE against A. flavus. and (E) PHE against A. niger. (F) PHE against P. italicum. (G) Comparison of antimicrobial activity of PHE against E. coli and S. aureus significantly, (a,b) non-identical letters denote statistical difference (p < 0.05). (H) Comparison of antimicrobial activity of PHE against C. albicans, A. flavus, A. niger, and P. italicum significantly, (a,b) non-identical letters denote statistical difference (p < 0.05).
3.3. Growth Inhibition of PHE Against A. flavus
Inhibitory activity of PHE against A. flavus was assessed using the mycelial growth rate. The results demonstrated that PHE exhibited a strong inhibitory effect on A. flavus mycelial growth in a dose-dependent manner. After 8 days, significant differences were observed among the different concentrations of PHE. At concentrations above 4 mg/mL, the growth of A. flavus mycelia began to be inhibited. At 16 mg/mL, PHE displayed the most potent inhibitory activity, achieving a 90.3% inhibition rate (Figure 2). Microbial metabolites serve as the principal source of antibiotics, with many microorganisms producing bioactive secondary metabolites during growth that exhibit potent antimicrobial activity against competing microbial species [33]. Sawai investigated that the culture filtrate of Streptomyces philanthi RL-1-178 showed increasing inhibition of A. flavus with increasing concentration. After further research, one of the main compounds was found to be natamycin [17]. The PHE, as an extract of Pseudomonas sp. HP-1 fermentation broth, showed potential antigens A. flavus activity, and the key factor may be the production of antifungal secondary metabolites. Li et al. have reported that Pseudomonas produced the secondary metabolite phenazine-1-carboxamide, which has excellent activity against the fungus Fusarium graminearum [34].
Figure 2.
Inhibition of A. flavus by PHE at different concentrations. (A) Effects of different concentration of PHE on colony morphology at day 8. Values at different concentration differ significantly (p < 0.05), and (B) effects of different concentration of PHE on colony diameter from day 1 to day 8.
3.4. Effect of PHE on Cell Morphology of A. flavus
SEM was conducted to assess the effect of PHE on A. flavus cell morphology. As shown in Figure 3, the surface of A. flavus mycelium in the control group was dense, thick, and intact. In contrast, the surface of the mycelium was rough and had grooves after treatment with PHE. Specifically, at a concentration of 16 mg/mL, the mycelium surface displayed roughness, dryness, and folds. These results indicated that PHE caused significant damage to the cell structure of A. flavus mycelium. The mechanism of antifungal action may primarily involve cytoplasmic contraction and alteration of cell membrane structure, ultimately leading to cell death. As the concentration of PHE increased, A. flavus exhibited progressively more pronounced morphological abnormalities. PHE exerted significant disruptive effects on cellular integrity, resulting in the leakage of intracellular contents. Similarly, Bacillus velezensis E2, a lipopeptide-producing strain, demonstrated significant anti-aflatoxin activity by inhibiting A. flavus spore germination, inducing abnormal hyphal swelling, and causing cellular rupture [35]. Yang et al. have also confirmed by SEM that Saccharomyces cerevisiae NJ-1 VOC-treated A. flavus showed severe abnormalities in mycelium morphology, including uneven surface, irregular thickness, and complete inhibition of spore formation [36].

Figure 3.
SEM images of A. flavus treated with different concentrations of PHE (Control, 8, 12, 16 mg/mL) for 24 h.
3.5. Effect of PHE on the Cell Membrane Integrity of A. flavus
To investigate the antifungal mechanism of PHE against A. flavus, propidium iodide (PI) staining was employed to assess cell membrane integrity (Figure 4). The results revealed an absence of red fluorescence in the control group, while the PHE-treated mycelia exhibited pronounced red fluorescence. As the concentration of PHE increased, the intensity of red fluorescence became more pronounced. This finding indicates that PHE treatment induced damage to the cellular membrane, consequently causing leakage of nucleic acid and protein in A. flavus, suggesting a potential mechanism of action involving impairment of membrane integrity.

Figure 4.
Effect of PHE on cell membrane of A. flavus. Cell membrane integrity of A. flavus analyzed using PI staining after 12 h of incubation with different concentrations of PHE.
3.6. Effect of PHE on the Maize Seed Infection by A. flavus
The effect of PHE on A. flavus contamination of maize seeds was then investigated. Changes in the morphology of A. flavus were observed after incubation for 7 days at different concentrations of PHE. The results demonstrated that PHE treatment significantly reduced aflatoxin contamination on maize seeds (Figure 5). Different doses of PHE (100, 200, and 300 mg/mL) inhibited the growth of A. flavus differently compared with the control values. Notably, the growth of A. flavus was completely inhibited in maize seeds treated with PHE (300 mg/mL) as compared to the control. There was no visible growth of A. flavus on maize seeds, while the control group treatment showed visible white mycelium on maize seeds. Furthermore, in the other treatment groups, even when a single maize seed was infected, infection did not spread rapidly throughout the plate. This suggested that the treatments were effective in limiting the spread of infection. Harvested maize is susceptible to pathogenic microorganisms. In particular, contamination by fungi such as A. flavus can produce the toxic and harmful substance aflatoxin [37]. Therefore, these findings concluded that the antifungal metabolite produced by Pseudomonas sp. HP-1 can be effectively applied as a partially purified extract (PHE), significantly reducing the cost associated with the purification process. This finding suggests that PHE is able to inhibit the antifungal compounds of Aspergillus sp. in a much simpler process. The results were in good agreement with the experiments carried out by Sawei, in which treatment of maize seeds with Streptomyces sp. culture filtrates reduced the development of fungi in stored maize seeds. [17]. PHE has strong inhibition of A. flavus, which may provide a new strategy for the prevention and control of maize diseases.
Figure 5.
Comparison of different concentrations of PHE on maize seeds after infection with A. flavus contamination.
3.7. Isolation and Structural Determination of Antifungal Compound in the PHE
The PHE exhibited significant antifungal activity against A. flavus, demonstrating a pronounced absorption peak at a retention time of 13.6 min during HPLC analysis. The extracts underwent sequential fractionation via silica gel chromatography, yielding seven fractions. Notably, the second fraction exhibited antifungal properties against A. flavus and matched the high absorption peak at the same retention time in HPLC. Therefore, the crude fraction was purified by preparative HPLC. Finally, the pure compound, designated as PHE A, was elucidated and characterized using mass spectrometry, as well as one- and two-dimensional NMR spectroscopy. The compound of PHE A was obtained as a yellow solid. The molecular formula was determined as C13H8N2O2 on the basis of the HRESITOFMS analysis, which gave a sodium adduct ion [M + Na]+ at m/z 247.0477 (calculated for C13H8N2O2Na, 247.0483). The combined analysis of 1H (Figure S3) and 13C (Figure S4) NMR and HSQC spectral data revealed the presence of one exchangeable proton (δH 15.53) and seven aromatic methine groups (δH 7.90, 7.94, 7.96, 8.19, 8.26, 8.44, 8.89). The 13C NMR spectrum displayed resonances for one carbonyl carbon (δC 165.9), seven non-protonated sp2 carbons (δC 144.0, 143.3, 139.9, 139.8, 124.9), and seven sp2 methine carbons (δC 137.4, 135.1, 133.2, 131.7, 130.2, 130.0, 127.9). The a-ring was established by COSY correlations among H2/H3/H4, showing a doublet-triplet-doublet coupling typical for 1-, 2-, and 3-trisubstituted benzene protons, together with HMBC correlations from H2 to C10a, H3 to C1 and C4a. Further HMBC correlations from H2 to carbonyl carbon C11 and exchangeable proton 11-OH to C1 suggested that a carboxylic acid group should be attached to C1. The b-ring was assembled from COSY correlations H6/H7/H8/H9 and HMBC correlations from H6 and H8 to C9a, and H9 to C5a. Finally, the structure of PHE A was determined to be phenazine-1-carboxylic acid (PCA) (Figure 6) [38] on the basis of almost identical 13C chemical shift data, as shown in Table S1.

Figure 6.
NMR data for PHE A. (A) 1H NMR spectrum of PHE A. (B) 13C NMR spectrum of PHE A. (C) COSY and key HMBC correlations for PHE A.
Phenazines represent a broad class of nitrogen-based heterocyclic secondary metabolites exhibiting redox-active aromatic properties, which are produced by diverse bacterial species through specialized biosynthetic pathways. Owing to their broad spectrum of biological activities, these compounds exhibit significant potential for applications in both agriculture and pharmaceuticals [39]. Among them, PCA has garnered considerable attention due to its high efficacy, low toxicity, and environmental compatibility, making it a promising agent for the prevention of fungal diseases across a wide range of crops [40]. The natural product PCA, an important microbial metabolite, is widely present in the secretions of microorganisms such as Pseudomonads and Streptomycetes [41]. The PCA has been demonstrated to exhibit remarkable structural stability and broad-spectrum antimicrobial activity against a variety of phytopathogens, including Xanthomonas oryzae (causing rice blight), Acidovorax citrulli (watermelon blight), Phytophthora capsica (chili pepper blight), Fusarium graminearum (wheat canker), Colletotrichum orbiculare (watermelon anthracnose), and Mycosphaerella brassicicola (rapeseed mycosphaerella) [42]. Furthermore, Gorantla et al. found that PCA exhibited excellent antifungal activity against A flavus, C. albicans, and P. expansum with zone of inhibition values of 17, 22, and 18 mm, respectively [43]. These properties underscore its potential as a versatile and effective agent for controlling plant diseases. Xun et al. have investigated the antifungal mechanism of PCA against Pestalotiopsis kenyana using transcriptomic analysis. Their findings revealed 3613 differentially expressed genes following PCA treatment, predominantly associated with redox processes and diverse metabolic pathways. Furthermore, PCA was observed to induce abnormal mycelial development, disrupt cell membrane integrity, reduce mitochondrial membrane potential, and elevate reactive oxygen species (ROS) levels [40]. In a separate study, Zhang et al. provided the first report on the marine-derived Pseudomonas aeruginosa PA31x, demonstrating its capability to synthesize PCA and regulate its biosynthesis via the phz1 and phz2 gene clusters [44]. These findings collectively underscore the multifaceted antimicrobial PCA.
4. Conclusions
In conclusion, the endophytic strain Pseudomonas sp. HP-1 isolated from Peganum harmala L. showed remarkable biocontrol capabilities. Its culture extract (PHE) exhibited potential antifungal properties and significantly inhibited the growth of fungal pathogens such as P. italicum, A. niger, and A. flavus. This highlights the potential of PHE as a sustainable biocontrol agent for the management of fungal diseases in agricultural applications. At a concentration of 16 mg/mL, PHE demonstrated near-complete inhibition of A. flavus mycelial growth. Furthermore, PHE significantly reduced the incidence of A. flavus contamination in stored agroecological maize seeds, with the treated PHE exhibiting enhanced antifungal activity compared to the untreated control, underscoring its potential as an effective antifungal agent for postharvest preservation. Through comprehensive NMR spectroscopy coupled with MS analysis, the primary bioactive constituent of PHE was identified as 1-phenazinecarboxylic acid (PCA), a compound known for its antimicrobial properties. This study provides a theoretical basis for the antifungal mechanism of PHE and highlights its potential application as a preservative in maize seed preservation.
Supplementary Materials
The following supporting information can be downloaded at: https://www.mdpi.com/article/10.3390/foods14101774/s1, Figure S1: HPLC-UV data for PHE; Figure S2: HRESIMS spectrum of PHE A (1); Figure S3: 1H NMR spectrum of 1 (600 MHz, CDCl3); Figure S4: 13C NMR spectrum of 1 (151 MHz, CDCl3); Figure S5: COSY spectrum of 1 (600 MHz, CDCl3); Figure S6: HSQC spectrum of 1 (600 MHz, CDCl3); Figure S7: HMBC spectrum of 1 (600 MHz, CDCl3); Table S1: Comparison of 13C chemical shifts of known PCA.
Author Contributions
M.K.: writing—review and editing, writing—original draft, methodology, formal analysis, data curation. L.X.: writing—review and editing, investigation, data curation, conceptualization. L.F.: writing—review and editing, data curation. R.W.—review and editing M.Z.—review and editing. N.W.: writing—review and editing, conceptualization. D.W.: writing—review and editing, formal analysis. Z.Z.: writing—review and editing, supervision, resources, project administration, funding acquisition, conceptualization. All authors have read and agreed to the published version of the manuscript.
Funding
This work was financially supported by Xinjiang Uygur Autonomous Region Tianchi Talent Introduction Program-Young Doctor under grant No. 5105240151f, Tianchi Innovation Leading Talent Project under grant No. 51052300410, and Natural Science Foundation of Xinjiang Uygur Autonomous Region Science and Technology Program Project No. 202499120007.
Institutional Review Board Statement
Not applicable.
Informed Consent Statement
Not applicable.
Data Availability Statement
The original contributions presented in this study are included in the article/Supplementary Materials. Further inquiries can be directed to the corresponding author.
Conflicts of Interest
The authors declare that they have no conflicts of interest.
References
- Erenstein, O.; Jaleta, M.; Sonder, K.; Mottaleb, K.; Prasanna, B.M. Global maize production, consumption and trade: Trends and R&D implications. Food Secur. 2022, 14, 1295–1319. [Google Scholar]
- Luo, N.; Meng, Q.F.; Feng, P.Y.; Qu, Z.R.; Yu, Y.H.; Liu, D.L.; Müller, C.; Wang, P. China can be self-sufficient in maize production by 2030 with optimal crop management. Nat. Commun. 2023, 14, 2637. [Google Scholar] [CrossRef] [PubMed]
- Luo, Y.; Huang, D.; Li, D.; Wu, L. On farm storage, storage losses and the effects of loss reduction in China. Resour. Conserv. Recycl. 2020, 162, 105062. [Google Scholar] [CrossRef]
- Różewicz, M.; Wyzińska, M.; Grabiński, J. The Most Important Fungal Diseases of Cereals—Problems and Possible Solutions. Agronomy 2021, 11, 714. [Google Scholar] [CrossRef]
- Katati, B.; Schoenmakers, P.; Njapau, H.; Kachapulula, P.W.; Zwaan, B.J.; van Diepeningen, A.D.; Schoustra, S.E. Preharvest Maize Fungal Microbiome and Mycotoxin Contamination: Case of Zambia’s Different Rainfall Patterns. Appl. Environ. Microbiol. 2023, 89, e00078-23. [Google Scholar] [CrossRef]
- Khan, R.; Anwar, F.; Ghazali, F.M. A comprehensive review of mycotoxins: Toxicology, detection, and effective mitigation approaches. Heliyon 2024, 10, e28361. [Google Scholar] [CrossRef]
- Massomo, S.M.S. Aspergillus flavus and aflatoxin contamination in the maize value chain and what needs to be done in Tanzania. Sci. Afr. 2020, 10, e00606. [Google Scholar] [CrossRef]
- Hell, K.; Cardwell, K.F.; Poehling, H.M. Relationship between Management Practices, Fungal Infection and Aflatoxin for Stored Maize in Benin. J. Phytopathol. 2010, 151, 690–698. [Google Scholar] [CrossRef]
- Martín, I.; Gálvez, L.; Guasch, L.; Palmero, D. Fungal Pathogens and Seed Storage in the Dry State. Plants 2022, 11, 3167. [Google Scholar] [CrossRef]
- Lamichhane, J.R.; You, M.P.; Laudinot, V.; Barbetti, M.J.; Aubertot, J.M. Revisiting Sustainability of Fungicide Seed Treatments for Field Crops. Plant Dis. 2020, 104, 610–623. [Google Scholar] [CrossRef]
- Wiederhold, N.P. Antifungal resistance: Current trends and future strategies to combat. Infect. Drug Resist. 2017, 10, 249. [Google Scholar] [CrossRef] [PubMed]
- Patel, O.P.S.; Jesumoroti, O.J.; Legoabe, L.J.; Beteck, R.M. Metronidazole-conjugates: A comprehensive review of recent developments towards synthesis and medicinal perspective. Eur. J. Med. Chem. 2021, 210, 112994. [Google Scholar] [CrossRef] [PubMed]
- Fisher, M.C.; Hawkins, N.J.; Sanglard, D.; Gurr, S.J. Worldwide emergence of resistance to antifungal drugs challenges human health and food security. Science 2018, 360, 739–742. [Google Scholar] [CrossRef] [PubMed]
- Zhang, H.Y.; Godana, E.A.; Sui, Y.; Yang, Q.Y.; Zhang, X.Y.; Zhao, L.N. Biological control as an alternative to synthetic fungicides for the management of grey and blue mould diseases of table grapes: A review. Crit. Rev. Microbiol. 2020, 46, 450–462. [Google Scholar] [CrossRef]
- Mishra, B.; Mishra, A.K.; Kumar, S.; Mandal, S.K.; NSV, L.; Kumar, V.; Baek, K.-H.; Mohanta, Y.K. Antifungal Metabolites as Food Bio-Preservative: Innovation, Outlook, and Challenges. Metabolites 2022, 12, 12. [Google Scholar] [CrossRef]
- Sun, J.; Zhou, Y.; Lu, Z.X.; Lu, Y.J. Bacillomycin D with calcium propionate effectively inhibited microbial growth and reduced deoxynivalenol on maize kernels during storage. J. Stored Prod. Res. 2023, 101, 102070. [Google Scholar] [CrossRef]
- Boukaew, S.; Mahasawat, P.; Petlamul, W.; Sattayasamitsathit, S.; Surinkaew, S.; Chuprom, J.; Prasertsan, P. Application of antifungal metabolites from Streptomyces philanthi RL-1-178 for maize grain coating formulations and their efficacy as biofungicide during storage. World. J. Microbiol. Biotechnol. 2023, 39, 157. [Google Scholar] [CrossRef]
- Li, S.; Cheng, X.; Wang, C. A review on traditional uses, phytochemistry, pharmacology, pharmacokinetics and toxicology of the genus Peganum. J. Ethnopharmacol. 2017, 203, 127–162. [Google Scholar] [CrossRef]
- Bibi, F. Diversity of antagonistic bacteria isolated from medicinal plant Peganum harmala L. Saudi J. Biol. Sci. 2017, 24, 1288–1293. [Google Scholar] [CrossRef]
- Pohanka, A.; Broberg, E.; Johansson, M.; Kenne, L.; Levenfors, J. Pseudotrienic Acids A and B, Two Bioactive Metabolites from Pseudomonas sp. MF381-IODS. J. Nat. Prod. 2005, 68, 1380–1385. [Google Scholar] [CrossRef]
- Loeschcke, A.; Thies, S. Engineering of natural product biosynthesis in Pseudomonas putida. Curr. Opin. Biotechnol. 2020, 65, 213–224. [Google Scholar] [CrossRef] [PubMed]
- Dimkić, I.; Janakiev, T.; Petrović, M.; Degrassi, G.; Fira, D. Plant-associated Bacillus and Pseudomonas antimicrobial activities in plant disease suppression via biological control mechanisms—A review. Physiol. Mol. Plant Pathol. 2021, 117, 101754. [Google Scholar] [CrossRef]
- Perez, J.P.Y.; Angarita, C.C.; Ochoa, O.D.S.; Restrepo, S.A.U. Development and validation of a HPLC-DAD method for determining the content of tryptamines in methanolic extracts of fruiting bodies of mushrooms belonging to species of the Psilocybe genus. Talanta 2025, 290, 127777. [Google Scholar] [CrossRef] [PubMed]
- Pakbin, B.; Brück, W.M.; Allahyari, S.; Rossen, J.W.A.; Mahmoudi, R. Antibiotic Resistance and Molecular Characterization of Cronobacter sakazakii Strains Isolated from Powdered Infant Formula Milk. Foods 2022, 11, 1093. [Google Scholar] [CrossRef]
- Chavez-Esquivel, H.; Cervantes-Cuevas, H.; Ybieta-Olvera, L.F.; Castañeda Briones, M.T.; Acosta, D.; Cabello, J. Antimicrobial activity of graphite oxide doped with silver against Bacillus subtilis, Candida albicans, Escherichia coli, and Staphylococcus aureus by agar well diffusion test: Synthesis and characterization. Mater. Sci. Eng. C 2021, 123, 111934. [Google Scholar] [CrossRef]
- Einloft, T.C.; de Oliveira, P.B.; Radünz, L.L.; Dionello, R.G. Biocontrol capabilities of three Bacillus isolates towards aflatoxin B1 producer A. flavus in vitro and on maize grains. Food Control 2021, 125, 107978. [Google Scholar] [CrossRef]
- Wang, B.; Zhang, G.; Yang, J.; Li, L.; Li, P.; Xu, S.; Feng, X.; Chen, Y. Evaluation of Inhibitory Effect and Mechanism of Euphorbia Factor L3 against Phytophthora capsici. Molecules 2023, 28, 2958. [Google Scholar] [CrossRef]
- Afzal, I.; Shinwari, Z.K.; Sikandar, S.; Shahzad, S. Plant beneficial endophytic bacteria: Mechanisms, diversity, host range and genetic determinants. Microbiol. Res. 2019, 221, 36–49. [Google Scholar] [CrossRef]
- Vannier, N.; Mony, C.; Bittebiere, A.K.; Michon-Coudouel, S.; Biget, M.; Vandenkoornhuyse1, P. A microorganisms’journey between plant generations. Microbiome 2018, 6, 79. [Google Scholar] [CrossRef]
- Stockwell, V.O.; Stack, J.P. Using Pseudomonas spp. for Integrated Biological Control. Phytopathology 2007, 97, 244–249. [Google Scholar] [CrossRef]
- Bull, C.T.; Stack, J.P.; Smilanick, J.L. Pseudomonas syringae Strains ESC-10 and ESC-11 Survive in Wounds on Citrus and Control Green and Blue Molds of Citrus. Biol. Control 1997, 8, 81–88. [Google Scholar] [CrossRef]
- Yang, R.H.; Du, X.N.; Khojasteh, M.; Shah, S.M.A.; Peng, Y.Z.; Zhu, Z.F.; Xu, Z.Y.; Chen, G.Y. Green guardians: The biocontrol potential of Pseudomonas-derived metabolites for sustainable agriculture. Biol. Control 2025, 201, 105699. [Google Scholar] [CrossRef]
- Bérdy, J. Bioactive Microbial Metabolites. J Antibiot. 2025, 58, 1–26. [Google Scholar] [CrossRef]
- Li, L.; Ran, T.; Zhu, H.; Yin, M.Y.; Yu, M.; Zou, J.P.; Li, L.W.; Ye, Y.H.; Sun, H.; Wang, W.W.; et al. Molecular Mechanism of Fusarium Fungus Inhibition by Phenazine-1-carboxamide. J. Agric. Food Chem. 2024, 72, 14. [Google Scholar] [CrossRef]
- Ma, J.; Gao, C.; Lin, M.; Sun, Z.; Zhao, Y.; Li, X.; Zhao, T.; Xu, X.; Sun, W. Control of Fusarium Head Blight of Wheat with Bacillus velezensis E2 and Potential Mechanisms of Action. J. Fungi. 2024, 10, 390. [Google Scholar] [CrossRef]
- Yang, T.; Wang, C.Z.; Li, C.J.; Sun, R.; Yang, M.G. Antagonistic effects of volatile organic compounds of Saccharomyces cerevisiae NJ-1 on the growth and toxicity of Aspergillus flavus. Biol. Control 2023, 177, 105093. [Google Scholar] [CrossRef]
- Grace, D.; Mahuku, G.; Hoffmann, V.; Atherstone, C.; Hari, D.; Upadhyaya, H.D.; Bandyopadhyay, R. International agricultural research to reduce food risks: Case studies on aflatoxins. Food Sec. 2015, 7, 569–582. [Google Scholar] [CrossRef]
- Lee, J.Y.; Moon, S.S.; Hwang, B.K. Isolation and in vitro and in vivo activity against Phytophthora capsici and Colletotrichum orbiculare of phenazine-1-carboxylic acid from Pseudomonas aeruginosa strain GC-B26. Pest. Manag. Sci. 2003, 59, 872–882. [Google Scholar] [CrossRef]
- Huang, W.; Wan, Y.; Zhang, S.; Wang, C.; Zhang, Z.; Su, H.; Xiong, P.; Hou, F. Recent Advances in Phenazine Natural Products: Chemical Structures and Biological Activities. Molecules 2024, 29, 4771. [Google Scholar] [CrossRef]
- Xun, W.; Gong, B.; Liu, X.; Yang, X.; Zhou, X.; Jin, L. Antifungal Mechanism of Phenazine-1-Carboxylic Acid against Pestalotiopsis kenyana. Int. J. Mol. Sci. 2023, 24, 11274. [Google Scholar] [CrossRef]
- Xiong, Z.P.; Niu, J.F.; Liu, H.; Xu, Z.H.; Li, J.K.; Wu, Q.L. Synthesis and bioactivities of Phenazine-1-carboxylic acid derivatives based on the modification of PCA carboxyl group. Bioorg. Med. Chem. Lett. 2017, 27, 2010–2013. [Google Scholar] [CrossRef] [PubMed]
- Bilal, M.; Yue, S.J.; Hu, H.B.; Wang, W.; Zhang, X.H. Adsorption/desorption characteristics, separation and purification of phenazine-1-carboxylic acid from fermentation extract by macroporous adsorbing resins. J. Chem. Technol. Biotechnol. 2018, 93, 3176–3184. [Google Scholar] [CrossRef]
- Gorantla, J.N.; Nishanth Kumar, S.; Nisha, G.V.; Sumandu, A.S.; Dileep, C.; Sudaresan, A.; Sree Kumar, M.M.; Lankalapalli, R.S.; Dileep Kumar, B.S. Purification and characterization of antifungal phenazines from a fluorescent Pseudomonas strain FPO4 against medically important fungi. J. Mycol. Médicale 2014, 24, 185–192. [Google Scholar] [CrossRef] [PubMed]
- Zhang, L.L.; Tian, X.Y.; Kuang, S.; Liu, G.; Zhang, C.S.; Sun, C.M. Antagonistic Activity and Mode of Action of Phenazine-1-Carboxylic Acid, Produced by Marine Bacterium Pseudomonas aeruginosa PA31x, Against Vibrio anguillarum In vitro and in a Zebrafish In vivo Model. Front. Microbiol. 2017, 8, 00289. [Google Scholar] [CrossRef]
Disclaimer/Publisher’s Note: The statements, opinions and data contained in all publications are solely those of the individual author(s) and contributor(s) and not of MDPI and/or the editor(s). MDPI and/or the editor(s) disclaim responsibility for any injury to people or property resulting from any ideas, methods, instructions or products referred to in the content. |
© 2025 by the authors. Licensee MDPI, Basel, Switzerland. This article is an open access article distributed under the terms and conditions of the Creative Commons Attribution (CC BY) license (https://creativecommons.org/licenses/by/4.0/).